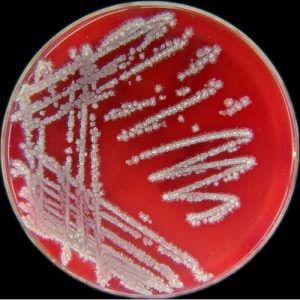

Giới thiệu về Hỗn hợp tế bào Lactic bất hoạt, tế bào Bacillus bất hoạt (số lượng chủng theo yêu cầu) – Dạng dịch
Hỗn hợp tế bào Lactic bất hoạt và tế bào Bacillus bất hoạt dạng dịch là sản phẩm kết hợp các chủng vi khuẩn Lactic và Bacillus sau khi đã được xử lý bất hoạt. Sản phẩm này mang lại nhiều lợi ích cho sức khỏe, đặc biệt trong việc hỗ trợ hệ tiêu hóa, tăng cường miễn dịch và bảo vệ cơ thể khỏi các tác nhân gây hại, đồng thời dễ dàng sử dụng trong các ứng dụng chế phẩm thực phẩm chức năng và chăm sóc sức khỏe.
Dưới đây là những thông tin chi tiết về Hỗn hợp tế bào Lactic bất hoạt, tế bào Bacillus bất hoạt dạng dịch:
1. Hỗn hợp tế bào Lactic và Bacillus bất hoạt là gì? Cơ chế hoạt động của sản phẩm
Hỗn hợp tế bào Lactic bất hoạt và tế bào Bacillus bất hoạt là sự kết hợp của các chủng vi khuẩn Lactic và Bacillus đã được nuôi cấy và xử lý để bất hoạt, nhằm đảm bảo các lợi ích sức khỏe mà không có khả năng sinh sôi. Sự bất hoạt này giúp sản phẩm an toàn cho sức khỏe, duy trì tác dụng hỗ trợ tiêu hóa và tăng cường miễn dịch mà không gây ra sự phát triển của vi khuẩn.
Cơ chế hoạt động:
- Duy trì cân bằng hệ vi sinh đường ruột: Các tế bào vi khuẩn bất hoạt hỗ trợ duy trì sự cân bằng hệ vi sinh trong đường ruột, từ đó ngăn ngừa sự phát triển của vi khuẩn có hại và thúc đẩy sự phát triển của vi khuẩn có lợi.
- Hỗ trợ tiêu hóa: Các vi khuẩn Lactic và Bacillus sản xuất các chất chuyển hóa có ích, giúp cải thiện chức năng tiêu hóa, tăng cường hấp thu chất dinh dưỡng và giảm các triệu chứng rối loạn tiêu hóa.
- Tăng cường miễn dịch: Các tế bào vi khuẩn bất hoạt có khả năng kích thích hệ miễn dịch, giúp cơ thể chống lại các tác nhân gây hại và giảm nguy cơ mắc các bệnh nhiễm trùng.
2. Vai trò và ứng dụng của Hỗn hợp tế bào Lactic và Bacillus bất hoạt
Hỗn hợp tế bào Lactic bất hoạt và Bacillus bất hoạt có những tác dụng quan trọng sau:
- Cải thiện chức năng tiêu hóa: Giúp điều hòa nhu động ruột, giảm táo bón, tiêu chảy và các rối loạn tiêu hóa khác.
- Tăng cường hệ miễn dịch: Các nghiên cứu cho thấy sản phẩm này giúp tăng cường sức đề kháng, giảm nguy cơ nhiễm trùng và các bệnh viêm nhiễm.
- Bảo vệ đường ruột: Các vi khuẩn trong sản phẩm giúp bảo vệ niêm mạc ruột, giảm viêm, đồng thời hỗ trợ phục hồi sự cân bằng hệ vi sinh đường ruột sau khi sử dụng kháng sinh hoặc bị rối loạn tiêu hóa.
- Giảm nguy cơ bệnh tật: Hỗ trợ giảm nguy cơ mắc các bệnh liên quan đến hệ tiêu hóa và viêm nhiễm đường ruột.
3. Đặc điểm nguyên liệu Hỗn hợp tế bào Lactic bất hoạt và Bacillus bất hoạt dạng dịch
- Dạng dịch: Thành phẩm ở dạng dịch trong suốt hoặc hơi đục, có mùi đặc trưng của vi khuẩn Lactic và Bacillus.
- Hoạt lực: Sản phẩm có thể cung cấp số lượng chủng vi khuẩn theo yêu cầu, đảm bảo hiệu quả tối ưu khi sử dụng.
- Tính chất: Sản phẩm tan hoàn toàn trong nước, dễ dàng hòa tan và sử dụng trực tiếp.
- Xuất xứ: Việt Nam.
- Đóng gói: Sản phẩm được đóng gói dưới dạng chai, thùng với các thể tích linh hoạt:
Chai: 250ml, 500ml, 1 lít, 2 lít, 5 lít, 10 lít. - Hạn sử dụng: 2 năm kể từ ngày sản xuất.
- Bảo quản: Sản phẩm cần được bảo quản ở nơi khô ráo, thoáng mát, tránh ánh sáng trực tiếp và nhiệt độ cao để duy trì chất lượng.
4. Lợi ích của sản phẩm
Hỗn hợp tế bào Lactic bất hoạt và Bacillus bất hoạt dạng dịch mang lại những lợi ích nổi bật cho sức khỏe:
- Hỗ trợ tiêu hóa: Giúp cải thiện khả năng tiêu hóa và hấp thu chất dinh dưỡng, đồng thời giảm các vấn đề như táo bón, đầy hơi và tiêu chảy.
- Tăng cường miễn dịch: Kích thích hệ miễn dịch, làm tăng khả năng chống lại các bệnh nhiễm trùng và viêm nhiễm.
- Bảo vệ và phục hồi đường ruột: Giúp bảo vệ niêm mạc ruột, giảm viêm nhiễm và phục hồi hệ vi sinh đường ruột, đặc biệt sau khi sử dụng kháng sinh hoặc bị rối loạn tiêu hóa.
- Giảm nguy cơ bệnh tật: Hỗ trợ giảm nguy cơ mắc các bệnh liên quan đến tiêu hóa và các bệnh viêm nhiễm.
Hỗn hợp tế bào Lactic bất hoạt và Bacillus bất hoạt dạng dịch là một giải pháp hiệu quả và an toàn để duy trì và cải thiện sức khỏe hệ tiêu hóa, tăng cường miễn dịch và bảo vệ cơ thể khỏi các tác nhân gây hại.

Đánh giá
Chưa có đánh giá nào.